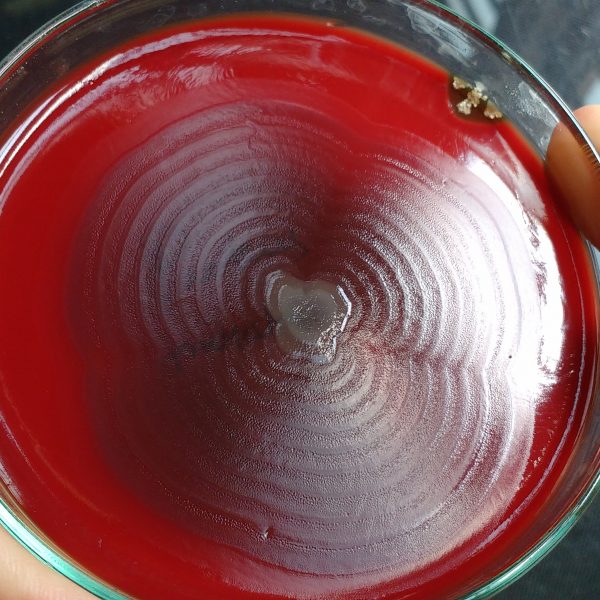
توکسین بایندر | خوراک دام | خوراک طیور |

خدمات
نمایش 17–24 از 58 نتیجه
-

بلاد آگار (Blood Agar )
ریال47,680–ریال87,980 انتخاب گزینه ها -

پرتئوس ( proteus sp )
اطلاعات بیشتر -

پروتئوس میرابیلیس (Proteus mirabilis)
اطلاعات بیشتر -

تالی رگولاتور
اطلاعات بیشتر -

تالی ژل داک
اطلاعات بیشتر -

تالی لومیناتور
اطلاعات بیشتر -

رایزوپوس اوری زایی (Rhizopus oryzae )
اطلاعات بیشتر -

ریزوبیوم (rhizobium sp)
اطلاعات بیشتر